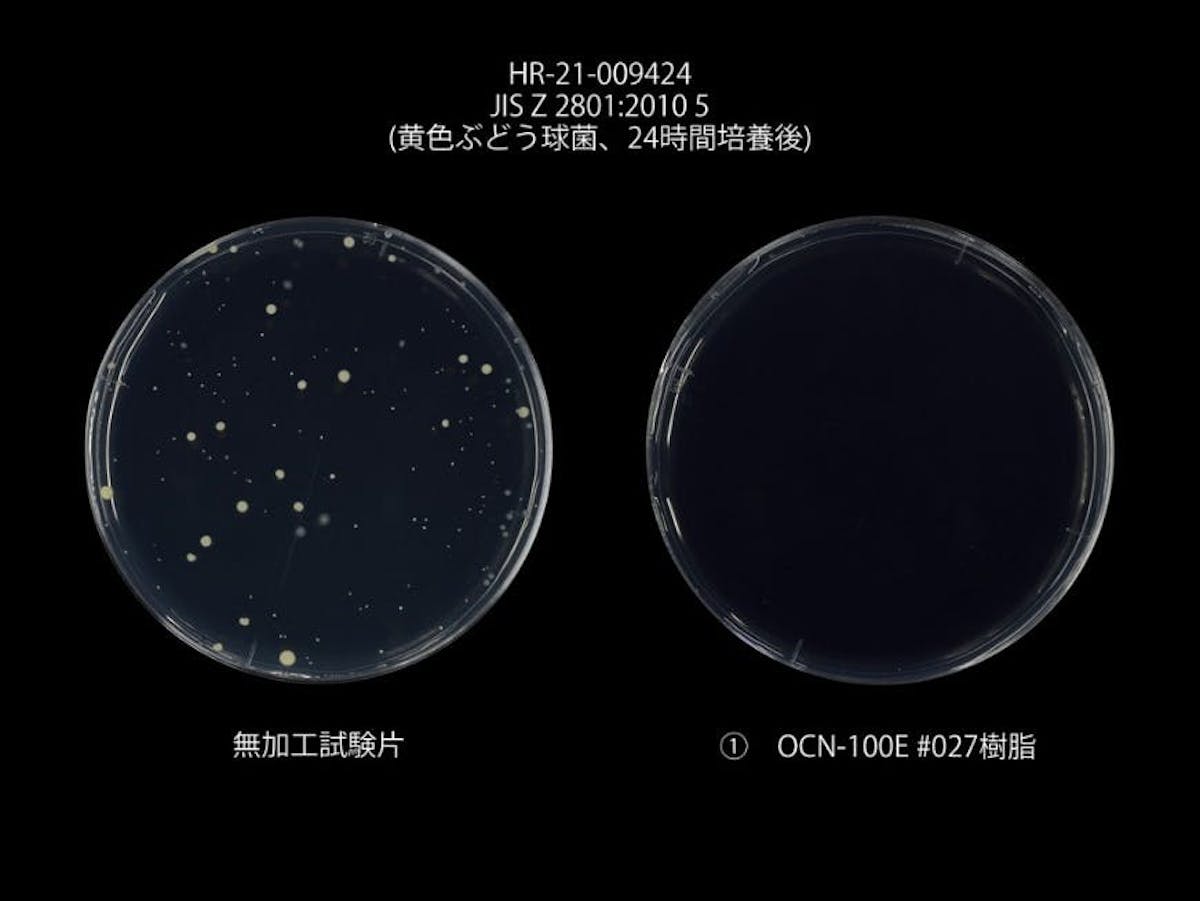
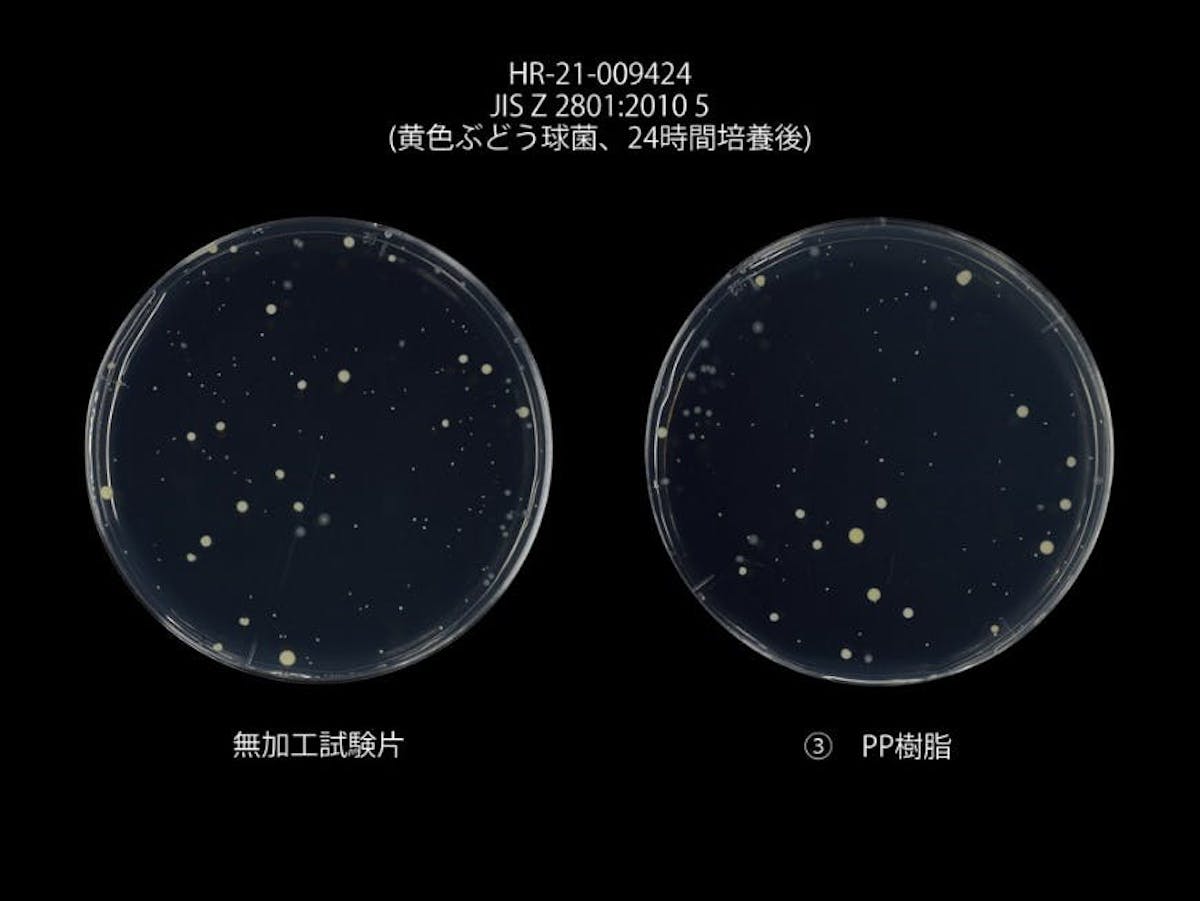
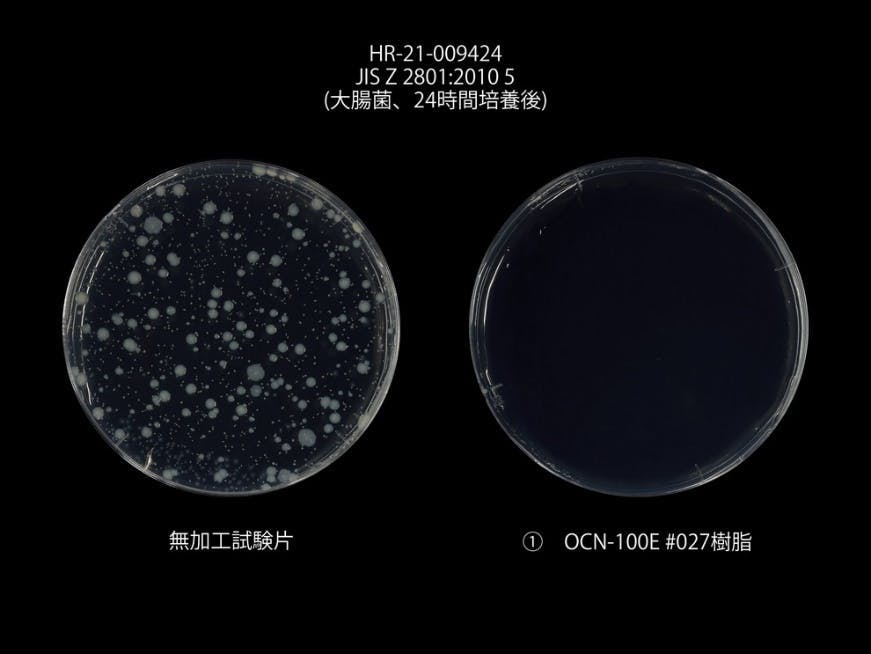
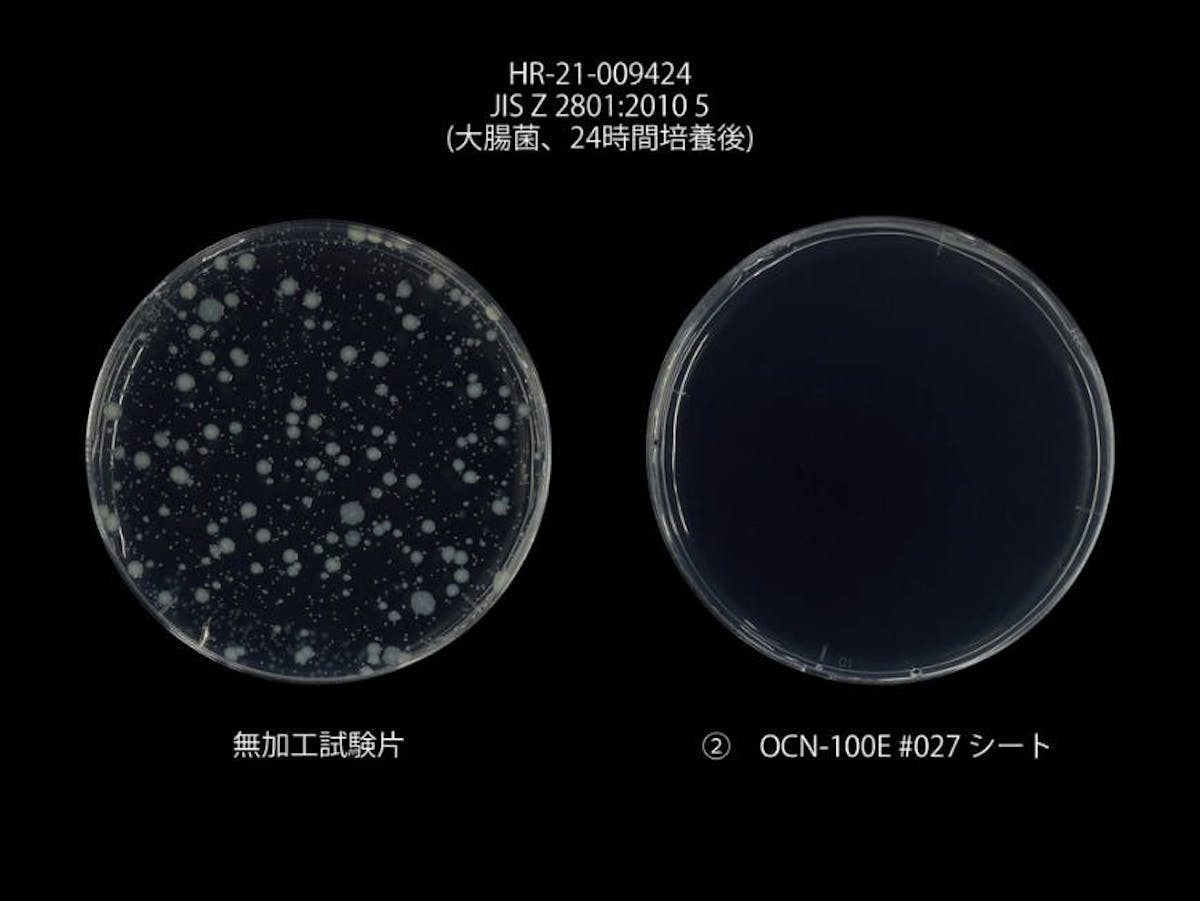
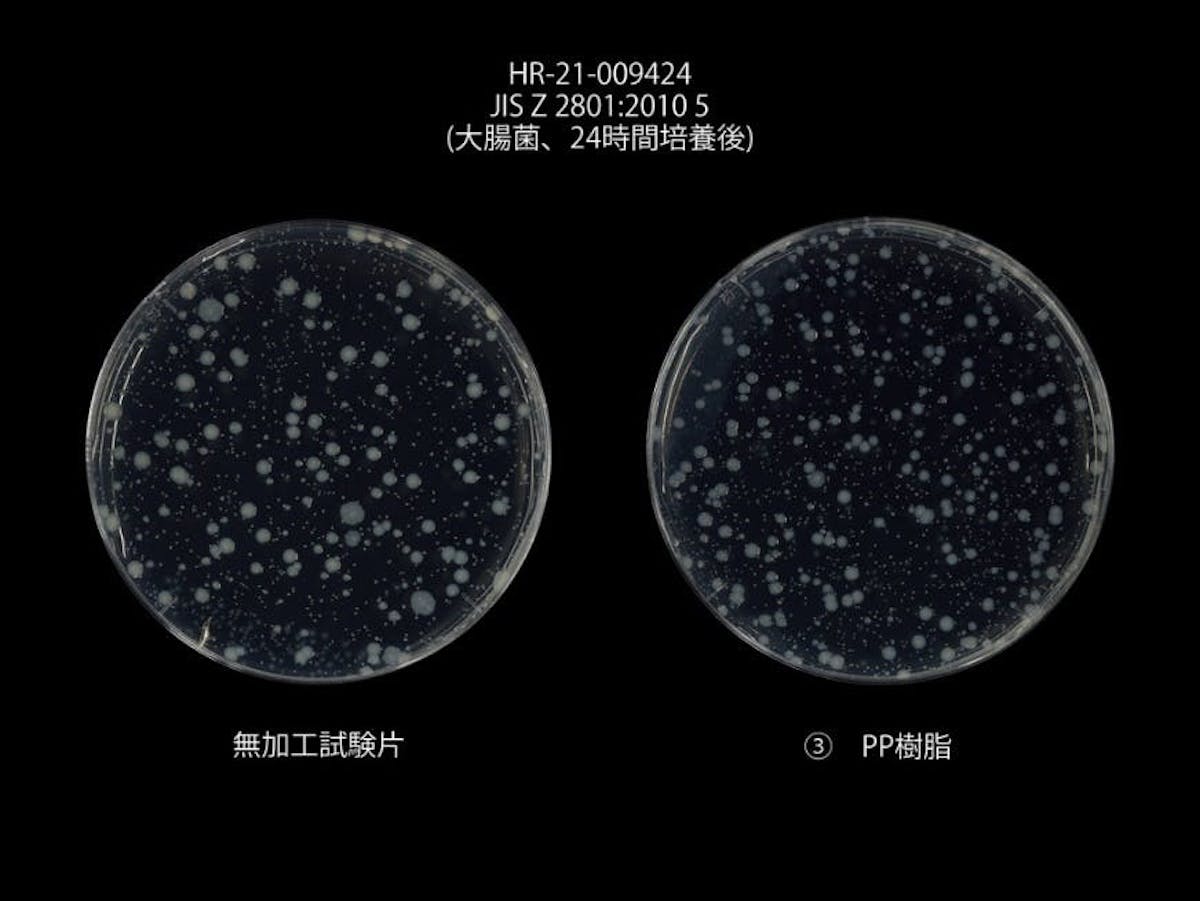

酢酸セルロースに非フタル酸の可塑剤を配合し世界初の透明性を有した海洋生分解性樹脂。
幅広い成型方法に対応したプラスチックのようでプラスチックではない新しい素材です。

自然環境において優れた生分解性
NEQAS OCEANは高い生分解性を持っています。
土壌での分解度試験では、僅か280日間で完全に分解されることが検証されました。
土壌だけではなく「海洋」「コンポスト(高温多湿)」微生物が生息する様々な環境下で分解が促進する、現代のプラスチック問題を根底から覆す環境性の高い素材です。
- JBPA(日本バイオプラスチック協会)の海洋性生分解性認証を取得

様々な成形に対応する柔軟な物性
セルロースを主原料とするNEQAS OCEANは、その繊維質により従来の樹脂と同等の高い靭性と、しなやかさを兼ね備えています。
これにより優れた物性を保つため様々な成形方法に対応しており、これまで通常のプラスチックを使用して生産していた製品も、同様の成形方法で生産が可能です。
強度・加工性をほぼそのまま活かした製品を自然に還る素材で制作することができます。

一般プラスチックのような透明性
NEQAS OCEANは従来の環境性樹脂で課題だった、透明度・濁ごりを解消し
一般のプラスチック(PET、アクリル等)のような透明性を有します。
NEQAS-OCEANを使用した成形実例はこちら
成形実例を見る
NEQAS OCEANの特徴

優れた生分解性
ほとんどの生分解材料は土壌分解止まりですが、NEQAS-OCEANは海洋分解性を有しています。
PLA | PBS | NEQAS OCEAN | |
コンポスト(高温多湿) | 〇 | 〇 | 〇 |
土壌環境 | × | 〇 | 〇 |
海洋環境 | × | △ | 〇 |
土壌中での生分解試験
試験規格 | JIS K 6955(ISO 17556) |
規格名称 | プラスチック-呼吸計を用いた酸素消費量又は発生した二酸化炭素量の測定による土壌中での好気的究極生分解度の求め方 |
試験温度 | 20~28 ℃ |
評価試料形態 | 冷凍粉砕した微粉末 |

海水中での生分解試験
試験規格 | OK biodegradable MARINE(ASTM D6691) |
規格名称 | 海水中で生分解が可能であり、そのコンポストが環境に安全(海洋生物の生育)であることを認証する。 |
試験温度 | 30 ℃ |
評価試料形態 | 微粉末 |

生態毒性試験
培養液に0.1%濃度の試料を添加し3カ月の養生後、その養生液でミジンコ(Daphnia)を48h培養し、ミジンコの活性を測定する。

高い抗菌作用で衛生面も安心
NEQAS OCEANは高い抗菌作用がある酢酸(お酢)が原料の一部です。
添加剤を加えなくても、お酢の力で高い抗菌効果を発揮します。
強い抗菌性を示す実験
試料 | NEQAS-OCN ペレット及びシート(0.3㎜) |
試験方法 | JIS Z 2801 |
抗菌性能基準 | 抗菌活性値2.0以上 |
試験菌 | 黄色ブドウ球菌・大腸菌 |
黄色ブドウ球菌

大腸菌

これまでの常識を覆すリサイクル性
NEQAS OCEANは最大5回のリサイクルを行なっても物性の劣化がほとんど発生しない、高いリサイクル性能を有しています。一般的な製品を一度素材に戻すリサイクル方法はもちろん、製品から別の製品へ姿を変えることができ、最後には土壌に分解されることで循環した素材のサイクルを行うことができる未来を見据えた素材です。
高いリサイクル性能を示す実験
